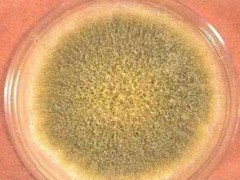
黃曲霉毒素B1檢測一下需要多少錢

鈦合金強度高、耐蝕性好、耐熱性高。鈦合金主要用于制作飛機發動機壓氣機部件,其次為火箭、導彈和高速飛機的結構件。鈦無毒、質輕、強度高且具有優良的生物相容性,是非常理想的醫用金屬材料,可用作植入人體的植入物等。
發布日期:05-04
黃曲霉毒素是一種毒性極強的物質。黃曲霉毒素的危害性在于對人及動物肝臟組織有破壞作用,嚴重時可導致肝癌甚至死亡。在天然污染的食品中,以黃曲霉毒素B1最為多見,其毒性和致癌性也最強。
發布日期:05-04
亞克力,化學名稱為聚甲基丙烯酸甲酯,是一種開發較早的重要可塑性高分子材料,具有較好的透明性、化學穩定性和耐候性,易染色,易加工,外觀優美。
發布日期:04-30
?隨著經濟社會的不斷發展,我國對于煤炭的需求量越來越大,與此同時對煤炭的質量也提出了更高的要求,這就需要對煤炭進行檢測。煤炭檢測工作有非常重要的意義,因為在煤炭貿易以及煤炭應用中,都需要以煤炭的檢測指標為依據,所以要將煤炭檢測工作重視起來。
發布日期:04-30
遮光眼罩的主要作用是遮擋光線、排除干擾,營造一個適合睡眠的環境,比較適合白天和戶外使用,比如中午休息,坐飛機、汽車時。
發布日期:04-30
中藥材是指來源于特定產區的具有中國特色的名優正品藥材,藥材質量好、療效好,在長期使用中得到了醫者與患者的普遍認可。
發布日期:04-30
防護口罩是防止呼吸道傳染疾病的有效防護用品之一,對于疫情控制與防護的作用舉足輕重。疫情防控過程中,各類仿冒制假的防護口罩事件不絕于耳,既不利于當前疫情的有效防控,也不利于老百姓的健康安全。
發布日期:04-30
一種可將整個耳廓罩住的護耳器。 防噪聲耳罩由弓架連接的兩個圓殼狀體組成,殼內附有吸聲材料和密封墊圈,整體形如耳機。適用于噪聲較高的環境,聲衰減量可達10~30db。可以單獨使用,也可以與耳塞結合使用。
發布日期:04-29
隔離衣用于醫務人員在接觸避免受到血液、體液、和其他感染性物質污染;用于保護患者避免感染的防護用品;隔離衣是既防止醫護人員被感染或污染又防止病人被感染,屬雙向隔離。
發布日期:04-29
彈子插芯門鎖重點檢測了互開率、鎖舌伸出長度等11個項目;球形門鎖重點檢測了互開率、鎖舌伸出長度、保險鎖舌保險功能等9個項目
發布日期:04-29
中藥是世界傳統醫學的重要組成部分,是中華民族的瑰寶。近年來,國際上十分關注中藥中重金屬元素的含量問題,對進口中藥均有明確規定。
發布日期:04-29
保鮮膜質檢報告辦理,保鮮膜產品的第三方質量檢測找質檢天下,保鮮膜是一種塑包裝制品,通常以乙烯為母料通過聚合反應制成。可分為聚乙烯(PE)、聚氯乙烯(PVC)和聚偏二氯乙烯(PVDC)三大類。
發布日期:04-29
?鮮蛋利用其自身防護機制可以抵御外界微生物的入侵,從蛋的外部結構來看,鮮蛋外面有三層結構,即外層蠟狀殼膜、殼、內層殼膜。每一層都在不同程度上有抵御微生物入侵的功能。
發布日期:04-28
鑒于鋼結構建筑的日益廣泛應用,鋼結構的安全關系到人們的生命安全,受到工業界的普遍重視,因此鋼結構檢測技術逐漸成為鋼結構產業發展重要的技術依托,而無損檢測技術因其在不損壞鋼結構構件的前提下可以全面快速地對鋼結構進行檢測,并作出正確的評估,逐漸成為鋼結構檢測的主要技術。
發布日期:04-28
?有色金屬是國民經濟、人民日常生活及國防工業、科學技術發展必不可少的基礎材料和重要的戰略物資。農業現代化、工業現代化、國防和科學技術現代化都離不開有色金屬。
發布日期:04-28
鋼產品鍍鋅層質量試驗方法有哪些?鋼產品檢測報告找哪個檢測平臺辦理比較好?質檢天下檢測平臺,可為您提供生鐵、鋼、鋼材、鐵合金
發布日期:04-27
無縫鋼管是一種具有中空截面、周邊沒有接縫的圓形,方形,矩形鋼材。無縫鋼管是用鋼錠或實心管坯經穿孔制成毛管,然后經熱軋、冷軋或冷撥制成。
發布日期:04-27
目前,常規的玩具測試標準主要包括中國玩具安全技術規范GB 6675,歐盟玩具安全標準EN 71,美國玩具安全標準ASTMF 963,美國聯邦消費品安全法令CPSA,消費品安全改進法案CPSIA,加拿大玩具法規SOR/2011-17,日本玩具安全標準ST 2016,國際玩具安全標準ISO 8124。
發布日期:04-27
鐵是世界上發現最早,利用最廣,用量也是最多的一種金屬。鐵礦石主要用于鋼鐵工業,冶煉含碳量不同的生鐵和鋼。鐵礦石是鋼鐵生產企業的重要原材料,天然礦石(鐵礦石)經過破碎、磨碎、磁選、浮選、重選等程序逐漸選出鐵。
發布日期:04-27
藥品包裝是指直接接觸藥品的包裝材料和容器,屬于專用包裝范疇,它具有包裝的所有屬性,并有其特殊性。
發布日期:04-25
近期正值春季氣溫回升快,風干物燥火易生是火災的高發季節,隨著新冠疫情的控制全國各地的生產生活已逐步正規,企業及住宅電量日益加大,警惕預防火災隱患,做好建材防火檢測成為至關重要的內容之一。
發布日期:04-25
食品調料多數是被用來作主食的調味品,也有少數可以當作主食來吃,例如洋蔥也可以為法國洋蔥湯等的主要蔬菜成分。調味料所添加的味道上分有酸、甜、苦、辣、咸、鮮,麻。添加的香氣上有甜香、辛香、薄荷香、果香等。
發布日期:04-24
鋼化玻璃是目前運用較為廣泛的安全玻璃形式,在建筑、汽車、家裝以及家電領域具有廣泛應用。隨著鋼化玻璃技術的不斷發展,鋼化玻璃的應用領域不斷擴大,人們對鋼化玻璃產品質量的要求不斷提高。
發布日期:04-24
鋰系電池分為鋰電池和鋰離子電池。手機和筆記本電腦使用的都是鋰離子電池,通常人們俗稱為鋰電池。
發布日期:04-23
有一種極具可逆性形變的材料,在室溫下彈性十足,在很小的作用力下也能產生很大的形變,除去外力后又能迅速恢復原形,這種材料叫做橡膠。
發布日期:04-23
酸是白酒發酵過程的產物,是許多微生物共同作用的結果,是賦予酒體愉快香氣的重要成分,同時也是生成對應酯類的前驅物質。
發布日期:04-22
“蘇丹紅”是一種化學染色劑,并非食品添加劑。它的化學成份中含有一種叫萘的化合物,該物質具有偶氮結構,由于這種化學結構的性質決定了它具有致癌性,對人體的肝腎器官具有明顯的毒性作用。
發布日期:04-22
鍍鋅是指在金屬、合金或者其它材料的表面鍍一層鋅以起美觀、防銹等作用的表面處理技術。主要采用的方法是熱鍍鋅。鍍鋅件在人類生產生活中的用處很廣,需要對其質量進行保證。因此,鍍鋅的檢驗也顯得尤為重要。
發布日期:04-22
在我國,醫用消毒巾是沒有明確標準來規范的。隨著新冠病毒的爆發,醫用消毒巾作為重要的醫療物資,對于消滅污染表面病毒、清潔血液、體液污染的表面環境,具有重要作用 ,也是醫院控制環境衛生,防止交叉感染的重要消毒用品。
發布日期:04-22
非織造布是紡織工業中最年輕而最有發展前途的一個新興領域。我國無紡布工業起步較晚,但發展十分迅速。發展初期的無紡布主要應用在服裝行業,作為輔料。
發布日期:04-21 一個工作日加急檢測
一個工作日加急檢測 7*24小時快速響應
7*24小時快速響應 十五年檢測經驗
十五年檢測經驗 檢測精準,價格透明
檢測精準,價格透明 超過百個檢測網點
超過百個檢測網點 客服熱線
客服熱線
